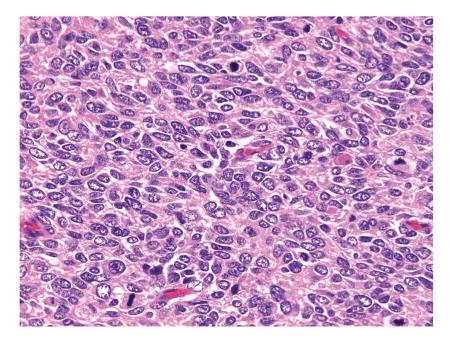

起源于腹膜后间隙的高分化骨外骨肉瘤复发为间变性梭形细胞肉瘤。
Well-differentiated extraskeletal osteosarcoma arising from the retroperitoneum that recurred as anaplastic spindle cell sarcoma.
作者信息
Arai Hiromasa, Rino Yasushi, Nishii Teppei, Yukawa Norio, Wada Nobuyuki, Oshiro Hisashi, Ishida Tsuyoshi, Nakaigawa Noboru, Masuda Munetaka
机构信息
Department of Pulmonary Medicine (Surgery), Yokohama City University Medical Center, 4-57 Urafune-cho, Minami-ku, Yokohama, 232-0024, Japan.
出版信息
Case Rep Med. 2010;2010:327591. doi: 10.1155/2010/327591. Epub 2010 Mar 4.
Extraskeletal osteosarcoma is an uncommon high-grade malignant soft tissue sarcoma. Well-differentiated extraskeletal osteosarcoma is thought to have a better prognosis than classical extraskeletal osteosarcoma, but dedifferentiation after recurrence has also been reported. We present a case of a primary retroperitoneal extraskeletal osteosarcoma in a 62-year-old Japanese woman. Abdominal CT revealed a large mass with diffuse calcification in the right retroperitoneal space and tumor resection was performed. The histopathological diagnosis was well-differentiated retroperitoneal extraskeletal osteosarcoma. She was followed up by CT every 6 months without adjuvant radiotherapy and chemotherapy for 31 months until anaplastic high-grade spindle cell sarcoma recurred in the retroperitoneum. Our case is the seventh reported description of well-differentiated extraskeletal sarcoma, and the first to arise in the retroperitoneum and recur as an entirely dedifferentiated spindle cell sarcoma.
骨外骨肉瘤是一种罕见的高级别恶性软组织肉瘤。高分化骨外骨肉瘤被认为比经典骨外骨肉瘤预后更好,但也有复发后去分化的报道。我们报告一例62岁日本女性原发性腹膜后骨外骨肉瘤病例。腹部CT显示右腹膜后间隙有一伴有弥漫性钙化的巨大肿块,遂行肿瘤切除术。组织病理学诊断为高分化腹膜后骨外骨肉瘤。在未进行辅助放疗和化疗的情况下,每6个月进行一次CT随访,持续31个月,直至腹膜后出现间变性高级别梭形细胞肉瘤复发。我们的病例是第七例报道的高分化骨外肉瘤描述,也是首例发生于腹膜后并复发为完全去分化梭形细胞肉瘤的病例。